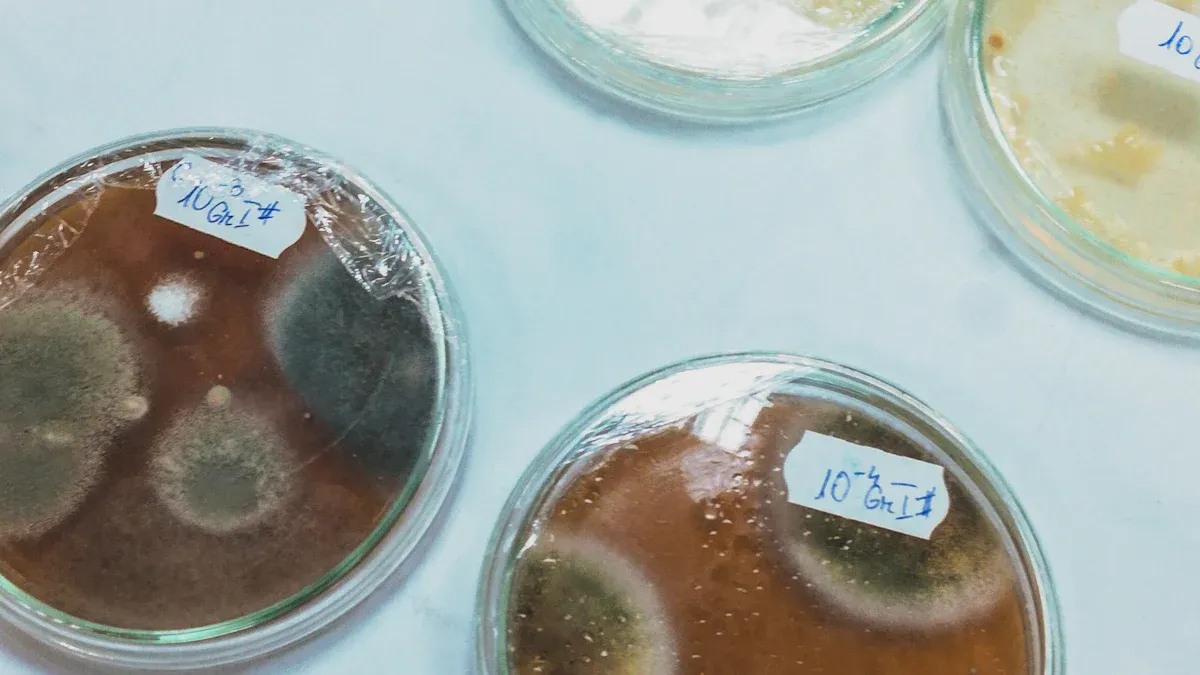
UNDERSTANDING THE ACTUAL RISK

Why This Appears Decoding Confusing Food Warnings

Have you ever wondered why this appears on a food package? Understanding the phrase "made in a facility that also processes..." is key for anyone with a food allergy. This statement does not mean the allergen is an ingredient.
It is a voluntary warning about potential accidental contact with an allergen. This is called cross-contamination.
This type of warning is a form of precautionary allergen labeling. You see this labeling often, especially on baked goods and snacks. The FDA does not require companies to use it.
This label on a product from a facility, like one that is made in a facility with nuts, signals a potential risk.
WHY THIS APPEARS: THE COMPANY'S VIEW
You see this label for a reason, and it starts with the company's process. The product itself does not contain the allergen as an ingredient. For example, a plain chocolate bar's recipe won't list nuts, soy, or eggs. The warning exists because of what happens in the factory. This is why this appears: to signal a potential for cross-contamination.
DEFINING CROSS-CONTAMINATION
Cross-contamination, also called allergen cross-contact, is the accidental transfer of an allergen to a food that should be free of it. This can happen in several ways within a manufacturing facility. Even with good cleaning practices, tiny particles of an allergen like nuts, soy, or eggs can find their way into another product.
Common sources of this allergen transfer include:
Shared Equipment: Using the same production line for chocolate with nuts and plain chocolate.
Airborne Particles: Flour or dust from nuts can travel through the air.
Personnel: Staff handling different products, like dairy and non-dairy items.
Rework: Adding leftover food (like cookie bits with soy) back into a new batch.
Even trace amounts of an allergen from dairy, eggs, or nuts can pose a problem. This is why this appears as a warning.
A VOLUNTARY LEGAL SAFEGUARD
Companies use this precautionary allergen labeling as a form of protection. The FDA requires mandatory labeling for the top eight allergens when they are ingredients. You will always see milk (dairy), eggs, soy, wheat, peanuts, and tree nuts listed clearly if they are part of the recipe.
However, the "made in a facility" warning is completely voluntary. Companies add this labeling to inform you about a potential risk and to protect themselves from legal liability.
A Tool for Safety and Liability This label serves two purposes. It helps protect the company from lawsuits in case of an accidental risk of allergic reaction. It also provides you with more information to make a decision based on your personal safety needs.
This voluntary labeling is the company's way of being transparent about its manufacturing environment, especially when foods with common allergens like nuts or soy are present.
UNDERSTANDING THE ACTUAL RISK
The biggest challenge with these warnings is understanding the actual level of danger. A "may contain" label does not tell you if the risk of an allergen is high or extremely low. This is why this appears as such a puzzle for consumers. The real risk depends on the company's cleaning rules, known as Good Manufacturing Practices (GMPs). The FDA now requires companies to focus on preventing allergen cross-contact, but the voluntary labeling does not quantify the risk for you.
AN UNQUANTIFIED DANGER
When you see a warning, you do not know the amount of allergen present. Is it a few particles or a more significant amount? The label doesn't say. This lack of clear labeling creates an unquantified danger for anyone with a food allergy. Some countries set specific limits. For example, Japan prohibits a "may contain" label if an undeclared allergen is below 10 parts per million (ppm). However, the U.S. has no such rule for these voluntary PAL warnings. A company with excellent cleaning might pose a very low risk. Another company with less strict controls could pose a higher risk, yet both use the same warning. This makes it hard for consumers to assess the true danger of an allergen.
INCONSISTENT AND CONFUSING WARNINGS
The phrasing of these warnings adds to the confusion. You might see "may contain nuts," "made on shared equipment," or "processed in a facility with soy." These different phrases all signal the same potential issue. This lack of standard labeling language hurts consumer understanding.
Studies show this inconsistency is a real problem. Researchers sometimes find no detectable allergen in products with PAL warnings. Other times, they find an allergen in products with no warning at all.
A perfect example of this confusing labeling involves gluten. A product can be certified "gluten-free," meaning it has less than 20 ppm of gluten. Yet, that same package might have a "may contain wheat" warning. This is allowed because the "gluten-free" claim is about the final, tested amount of gluten, while the "may contain" warning is a voluntary statement about the factory environment. This shows how important clear labeling is for consumers managing a gluten sensitivity or wheat allergen.
YOUR FOOD ALLERGY AND MAKING A SAFE CHOICE

You now understand why these confusing warnings appear. The next step is learning how to navigate them for your own health. Making a safe choice depends entirely on your personal food allergy and your specific dietary restrictions. For some consumers, these products are fine. For others, they pose a serious risk.
ASSESSING PERSONAL RISK
Your personal risk level is the most important factor. To assess it, you first need to understand your condition. Is it a food allergy or a food intolerance? The two are very different. A food intolerance affects your digestive system, while a food allergy involves your immune system and can be life-threatening. Many consumers must manage their dietary restrictions carefully.
A food intolerance might cause discomfort, but a food allergy can cause a severe reaction called anaphylaxis. Even a microscopic amount of an allergen can trigger this.
Knowing the difference helps you understand the stakes. If you have a mild intolerance, you might be able to eat small amounts of a food. If you have a true food allergy, you must avoid the allergen completely. The table below shows how symptoms can differ.
Reaction Severity | Symptoms You Might Experience |
|---|---|
Mild to Moderate | Itchy mouth, a few hives, mild nausea, or stomach discomfort. |
Severe (Anaphylaxis) |
A severe reaction can involve any severe symptom or even mild symptoms that affect more than one part of your body (like hives plus an upset stomach). Your personal sensitivity to an allergen also plays a big role. Several factors determine this:
Genetics: A family history of allergies increases your risk.
Allergen Type: Some allergens, like peanuts, carry a higher risk for severe reactions than others, such as soy.
Amount Ingested: The quantity of allergen you consume directly impacts the reaction.
Your Body's Defenses: The health of your digestive system can influence your sensitivity.
For anyone with a diagnosed, life-threatening food allergy, allergists give clear advice. They recommend you avoid products with these precautionary labels. The risk is unquantified, making it a gamble not worth taking for your safety. Managing these dietary restrictions is key to your well-being.
STEPS FOR MORE INFORMATION
If you do not have a severe food allergy or want to investigate a product further, you can take steps to get more allergen information. This helps consumers with dietary restrictions make more informed choices.
1. Contact the Manufacturer 📞 The most direct way to get answers is to ask the company. Many companies have detailed allergen information on their websites. For example, The Hershey Company explains its cleaning procedures and how it separates allergens. You can call or email the company's consumer relations department. Ask specific questions about their manufacturing process for the product you are interested in. This is a great step for all consumers managing dietary restrictions.
2. Look for Third-Party Certifications ✅ Some products carry certifications that guarantee strong allergen controls. A program like Certified Free From (CFF) performs in-person audits and tests products to ensure they are free from the top nine allergens. These certifications provide a higher level of trust and are a great tool for managing your dietary restrictions. They offer peace of mind that goes beyond a simple label.
3. Use Technology and Apps 📱 Several mobile apps can help you manage your dietary restrictions. Apps like Fig, ContentChecked, or Allergy Force allow you to scan a product's barcode. The app then checks the ingredients against your specific allergies and dietary restrictions. While these tools are helpful, they are not a substitute for reading the label yourself. Always use them as a secondary source of allergen information.
4. Report Issues and Stay Informed 🏛️ Your experience can help improve consumer safety. If you have a reaction to a product you thought was safe, you can report it. This helps regulatory bodies track problems and protect other consumers. FARE (Food Allergy Research & Education) provides guidance on how to contact the correct agency.
Regulatory Body | How to Contact Them |
|---|---|
FDA | Phone: (301) 436-2405 or use the online Safety Reporting Portal. |
USDA | Phone: (888)-674-6854 or visit their website's contact page. |
Staying informed about your allergies and how to read labels is the best way to manage your dietary restrictions and ensure you make safe choices. Getting clear allergen information is your right as a consumer.
These labels signal a potential risk, not a guarantee of an allergen. They are a tool for risk management. Your personal food allergy dictates your choice.
For your safety, most allergists and FARE recommend you avoid these products if your reaction could be severe.
For milder issues, you can investigate further. The FDA is updating its guidance, and consumer petitions are pushing for clearer rules, signaling that labeling may soon improve.
FAQ
### What is the difference between "may contain" and "made in a facility"?
Both are voluntary warnings about potential cross-contact with an allergen. Companies choose the wording. You should treat these different phrases as signals of the same potential risk. Your personal allergy dictates how you should interpret the warning.
### Is it safe to eat these products if I have a food allergy?
If you have a severe or life-threatening food allergy, experts advise you to avoid these products. The risk is unknown. For a mild intolerance, you might decide the risk is acceptable, but you should always proceed with caution.
### Does the FDA require these "may contain" labels? ❌
No, the FDA does not require these warnings. They are completely voluntary. The FDA only requires companies to list the top nine allergens when they are actual ingredients. Companies must also work to prevent cross-contact in their facilities.
### Why does a "gluten-free" product say "may contain wheat"? ✅
A "gluten-free" certification means the final product tests below a certain gluten level (20 ppm). The "may contain wheat" warning is a separate, voluntary statement about the factory environment. The product meets the gluten-free standard despite the factory risk.